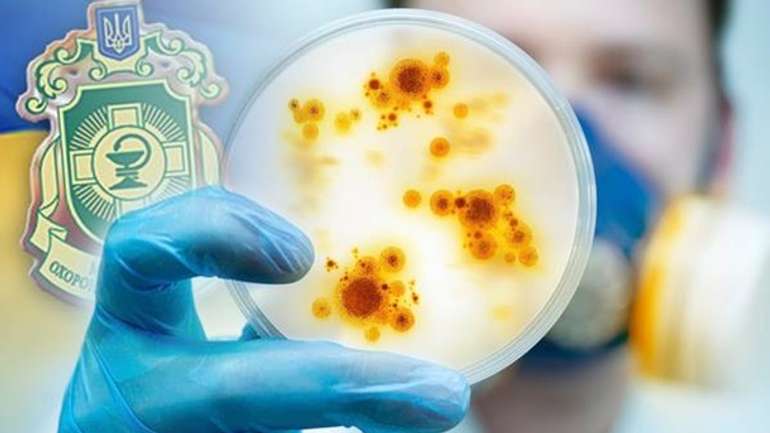

МОЗ веде переговори з міжнародними організаціями про гуманітарну вакцину проти ботулізму – лікар
Євген Гончар, сімейний лікар, член громадської ради МОЗ. VOX-Connector, для «Останнього Бастіону».
Спалахи ботулізму відбуваються сезонно. І червневий спалах був цілком прогнозованим.
У минулому році було зафіксовано близько ста випадків, з початку цього року, за даними Міністерства охорони здоров'я, 62 випадки, дев'ять із яких летальні.
Джерелом ботулізму є продукти харчування – зазвичай, це в'ялена та копчена риба, і м'ясо, ковбаси, гриби, овочі.
У цьому році у більшості випадків причиною була придбана у супермаркетах в'ялена риба. За зовнішнім виглядом або якимось іншими показниками зрозуміти чи є в продукті збудник ботулізму чи немає – неможливо.
Саме тому на літній сезон, особливо за умови відсутності сироватки та спалаху захворювання рекомендую виключити з продуктів харчування в'ялену рибу, м’ясо. У разі ж підозри (вздута упаковка, наприклад) продукт краще викинути або ж просмажити чи прокип’ятити.
В залежності від кількості збудника та його серотипу ботулізм може проявляється по різному. Зіпсований продукт може з’їсти кілька людей, а захворіти – лише один, той, у кого збудник ботулізму та токсин у шматку їжі знаходився у достатній концентрації.
Розрізняють неспецифічні (спостерігаються при звичайних отруєннях) та специфічні симптоми ботулізму.
Неспецифічні – це нудота, біль у животі, блювання.
Специфічні – сухість у роті, зміна голосу, порушення зору, м’язова слабкість, опущення верхніх повік, порушення ковтання, порушення дихання.
Симптоми можуть проявитися через годину, через кілька днів, а можуть і взагалі через десять днів. Миттєва форма прояву ботулізму – дуже небезпечна. У цьому випадку час іде на години, для того щоб не допустити летального випадку лікування потрібно почати якомога швидше.
Яка зараз ситуація з ліками?
До 2014 року МОЗ закуповував сироватку у Росії. Потім набули чинності нові регуляторні акти, за якими виробникам потрібно надавати GMP сертифікат – міжнародний сертифікат якості. Російським виробникам, згідно з російським законодавством, цей сертифікат не потрібен, а питання забезпечення цими ліками має безпековий характер. Саме через відсутність цього сертифікату сироватку неможливо зареєструвати в Україні.
У свою чергу європейські виробники, які мають цей сертифікат, не подавали заявки на реєстрацію та поставки в Україну. Можливо, через те, що потрібна дуже обмежена кількість сироватки.
Відповідальність за закупку цих ліків лежить на місцевих органах влади, але через відсутність зареєстрованих в Україні виробників, вони не змогли її закупити. Саме через це сироватки не закуповувались з 2014 року.
Сьогодні виходом із ситуації може бути внесення зміни у державний бюджет, та виділення додаткових коштів на закупку ліків через міжнародні організації – ПРООН, ЮНІСЕФ, Crown agency. Наскільки мені відомо, європейська сироватка коштує значно дорожче російської, близько 4 тис. доларів.
Варіант із внесенням змін до бюджету не дуже ймовірний. Як мінімум – він не оперативний. Внесення змін у законодавство – це тривалий процес. До того ж потрібен додатковий час на оголошення тендерів та оформлення необхідної документації.
Складність у тому, що коло використання цього препарату дуже обмежене, тому його не можна просто придбати в аптеках у сусідніх країнах. Його виробляють тільки в об’ємах, потрібних для виконання поставок за вже підписаними контрактами. Тому навіть якщо звернутися до міжнародних компаній з проханням поставити препарат в Україну за кошти або без них – вони його можуть просто не мати.
Наскільки мені відомо, МОЗ веде переговори про те, щоб міжнародні організації надали нам вакцину як гуманітарну допомогу.
Чекаємо, що з цього вийде.
Сьогодні при випадках ботулізму родичі хворого самотужки шукають сироватку: через знайомих медиків, через оголошення в Інтернеті намагаються вийти на «сірі» та «чорні» поставки з Білорусі та Росії.
Вживати такі препарати – це великий ризик, оскільки невідомо, де зберігався цей препарат, наскільки він якісний.
Що робити в результаті робити у випадку з ботулізмом?
Необхідно спробувати знайти сироватку, а також максимально швидко звертатися у лікарні. Хворого слід госпіталізувати у інфекційну реанімацію, де хворий отримає необхідну допомогу. Мова йде штучну вентиляцію легень, промивання шлунку та інші заходи. І навіть при відсутності сироватки у лікарні нададуть допомогу, яка значно збільшить шанси на успішне лікування.
Також необхідно зазначити, що схожа ситуація може нас очікувати і з іншими інфекційними захворюваннями: дифтерія, сказ, правець, малярія, отруєння від укусів змій та павуків, ліків для них також немає. Тому я раджу обов’язково вакцинуватись, щоб мінімізувати ризики.